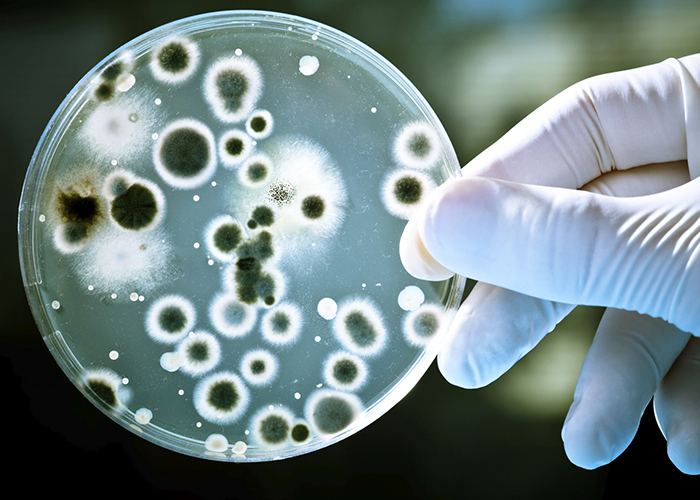

14/04/2021 - Equipe Target
NBR ISO 21527-1 de 03/2021 - Microbiologia de alimentos para consumo humano e animal - Método horizontal para enumeração de leveduras e bolores - Parte 1: Técnica de contagem de colônias em produtos com atividade de água superior a 0,95
A NBR ISO 21527-1 de 03/2021 - Microbiologia de alimentos para consumo humano e animal - Método horizontal para enumeração de leveduras e bolores - Parte 1: Técnica de contagem de colônias em produtos com atividade de água superior a 0,95 especifica um método horizontal para a enumeração de leveduras e bolores viáveis em produtos destinados ao consumo humano ou animal com atividade de água superior a 0,95 [ovos, carnes, laticínios (exceto leite em pó), frutas, vegetais, pastas frescas etc.], por meio da técnica de contagem de colônias a 25 °C ± 1 °C.
Essa parte não permite a enumeração de esporos de fungos. Nem a identificação da microbiota de fungos nem o exame de alimentos para micotoxinas estão dentro do escopo desta parte. O método especificado nesta parte da não é adequado para a enumeração de fungos resistentes ao calor, como Byssochlamys fulva ou Byssochlamys nivea, em frutas e vegetais enlatados ou engarrafados.
Target Genius Respostas Diretas:Por que fazer a adição opcional de oligoelementos?
Qual deve ser a aparelhagem e vidraria a ser usada?
Como preparar a alíquota de ensaio, suspensão inicial e diluiç&otil...